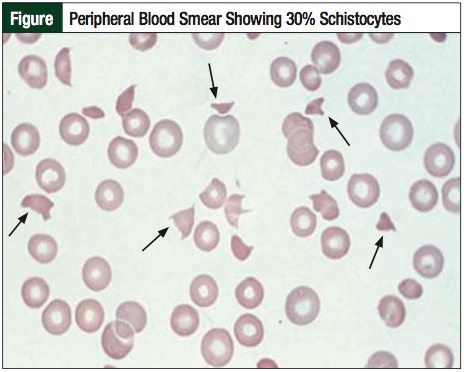

Dr Montoro is a Hematologist, Department of Hematology and Medical Oncology, Hospital Clínico Universitario; Dr Gómez is a Hematologist, Department of Hematology and Medical Oncology, Hospital Clínico Universitario; Dr Tormo is a Hematologist, Department of Hematology and Medical Oncology, Hospital Clínico Universitario; Dr Torrecillas is a Pharmacologist, Department of Pharmacy, Hospital Clínico Universitario; and Dr Calabuig is a Hematologist, Department of Hematology and Medical Oncology, Hospital Clínico Universitario, Valencia, Spain.
Background: Acute myeloid leukemia (AML) is a malignant blood disorder that is characterized by blocked or impaired differentiation of hematopoietic stem cells. Drug-associated thrombotic microangiopathy (TMA) has been recognized for several years, but there is ambiguity regarding this diagnosis, and any relationship between drug exposure and the onset of TMA symptoms.
Objective: To describe the case of a patient with AML with myelodysplasia-related changes who developed TMA after the first cycle of fludarabine plus high-dose cytarabine, idarubicin, and granulocyte colony-stimulating factor (FLAG-IDA).
Discussion: A 65-year-old woman with secondary AML received chemotherapy with a regimen of FLAG-IDA. On day 4 of the cycle, the patient developed oliguria and generalized edema. Laboratory findings revealed renal dysfunction, hemolysis, and low platelet count. The peripheral blood smear showed 30% schistocytes. The development of renal failure, microangiopathic hemolytic anemia, and neurologic deterioration during the treatment with the FLAG-IDA regimen led to the diagnosis of drug-induced TMA. Despite the prompt implementation of supportive treatment and the immediate discontinuation of the drug, the prognosis was fatal.
Conclusion: Chemotherapy-induced TMA is of considerable clinical importance, because of the abrupt onset, fulminant clinical course, and high morbidity and mortality. To our knowledge, this is the first case to describe the association of TMA with the first cycle of FLAG-IDA. Healthcare professionals should be more aware of the possibility of a patient developing chemotherapy- induced TMA to ensure rapid initiation of appropriate treatment.
Acute myeloid leukemia (AML) is a malignant blood disorder that is characterized by blocked or impaired differentiation of hematopoietic stem cells, resulting in the abnormal accumulation of immature precursors, the suppression of growth, and the maturation of normal hematopoiesis. The use of a regimen that combines fludarabine plus high-dose cytarabine (arabinofuranosyl Cytidine), idarubicin, and granulocyte colony-stimulating factor (G-CSF) and is known as “FLAG-IDA” is an effective treatment for patients with refractory or with relapsed AML. The FLAG-IDA regimen shows evidence of antileukemic activity in patients with high-risk myeloid malignancies and has an acceptable toxicity. Myelosuppression and infections resulting from neutropenia are the most frequent adverse effects associated with this regimen of drugs.1
Thrombotic thrombocytopenic purpura and hemolytic- uremic syndrome (TTP-HUS) is a concept that involves a group of common disorders, such as thrombocytopenia, microangiopathic hemolytic anemia, and the functional impairment of various organs, resulting from platelet agglutination in the arterial microvasculature.2 Because of a considerable overlap between the clinical presentation and the morphologic findings of both disorders—TTP and HUS—these 2 syndromes are now increasingly referred to as thrombotic microangiopathy (TMA). Many factors are associated with the development of TMA, including infections, autoimmune disorders, malignancy, and a variety of drugs.3
Drug-associated TMA has been recognized for several years, but many cases are difficult to interpret, because of the uncertainty regarding its diagnosis and the relationship between the drug exposure and the onset of the clinical manifestations. The mechanism of drug-induced TMA is primarily immune-mediated or is a result of direct toxicity.4 Although uncommon, TMA is of considerable clinical importance, because of its abrupt onset, fulminant clinical course, and the associated high morbidity and mortality in the absence of early recognition and treatment.4 Cases related to direct toxicity of a drug usually have a poor prognosis.
We report the case of a 65-year-old woman who was diagnosed with AML associated with myelodysplasia-related changes and who developed TMA after the first cycle of the FLAG-IDA regimen. To our knowledge, this association has not been described in the literature to date.
Case Description
A 65-year-old woman was diagnosed with myelodysplastic syndrome (MDS) with refractory anemia subtype and an excess of blasts (RAEB)-2. Her medical history was unremarkable, except for an allergy to penicillin. At diagnosis, a bone marrow aspirate revealed dyserythropoiesis, including megaloblastoid changes of erythroid precursors; multinuclearity; nuclear fragmentation and unstained area in the cytoplasm (dyshemoglobinization); dysgranulocytopoiesis, including hypogranular neutrophils and pseudo-Pelger-Huët anomaly of neutrophils and dysmegakaryocytopoiesis with micromegakaryocytes; large mononuclear forms; and multiple separate nuclei. The bone marrow blast percentage was 12%. Based on the World Health Organization (WHO) 2008 classification of MDS, a diagnosis of RAEB-2 was made.
The cytogenetic abnormalities showed a complex karyotype with deletion of chromosome 5, del(5)(q13q31). Fluorescence in situ hybridization detected amplification of the MLL and 5q deletion in 70% of the nucleus.
The patient was treated with a hypomethylating agent, 5-azacytidine, administered subcutaneously at 75 mg/m2 daily for 7 days of every 28-day cycle for 6 cycles, without complications.
The bone marrow aspirate after treatment showed a transformation to an AML, with 43% of blasts. The patient’s initial physical examination was unremarkable (performance status 0), and her complete blood count included a white blood cell (WBC) count of 9.67 × 10³/µL, hemoglobin 88 g/L, and platelets 155 × 10³/µL. The baseline creatinine level was 0.62 mg/dL and the liver enzymes and coagulation parameters were normal (Table 1).
The patient had a good performance status, without infection or bleeding complications. Cytogenetic abnormalities were the same as at diagnosis, and molecular studies revealed no mutations in the nucleophosmin and the FLT3-ITD gene.
The patient was diagnosed with an AML associated with myelodysplasia-related features, as defined by the 2008 WHO classification system, with poor prognosis. She was then started with the FLAG-IDA regimen chemotherapy.
Two days after the beginning of chemotherapy, the patient developed fever. Laboratory evaluation revealed a WBC count of 5.2 × 10³/µL, without microbiologic documentation or changes in chest radiography. Renal function, coagulation parameters, and liver enzymes were normal. No symptoms or signs of clinical infection were evident. Antibiotic therapy was started empirically, with tigecycline and amikacin.
On day 4 of the first chemotherapy cycle, the patient presented with oliguria and generalized edema. Laboratory findings revealed renal function impairment, a decrease in the platelet count, and hemolysis that was suggested by elevated lactate dehydrogenase, decreased haptoglobin concentration, and elevated indirect bilirubin. A urinary tract ultrasound showed no signs of obstruction. The peripheral blood smear revealed 30% schistocytes per high-power field (Figure). Partial thromboplastin and prothrombin time were within normal limits.
This led to the suspicion of chemotherapy-induced TMA, and we initiated supportive treatment. Chemotherapy was stopped, and the patient received hemodialysis and transfusion support. In the next 24 hours, laboratory tests revealed progressive hemoglobin and a decrease in platelet count, with urea and creatinine elevation. The patient received hemodialysis daily between days 4 and 7, without any clinical or analytical improvement (Table 1).
On day 8, the patient developed uremic encephalopathy and respiratory insufficiency, with a suspected alveolar hemorrhage, and she died hours later. Because of the abrupt onset, the fatal prognosis of the symptoms, and the suspected diagnosis of drug-induced TMA, we did not carry out a determination of ADAMTS13 (a disintegrin and metalloproteinase with thrombospondin type 1 motives). Table 2 shows a complete list of all the medications that the patient started and stopped using during this period.
The development of a microangiopathic hemolytic anemia, renal failure, and neurologic deterioration during the treatment with the FLAG-IDA regimen led us to a diagnosis of drug-induced TMA. Despite the prompt implementation of the supportive treatment and the immediate discontinuation of the chemotherapy, the disease had unfavorable development and no response to hemodialysis, which resulted in a fatal outcome.
Discussion
Compared with the general population, patients with cancer show an increased susceptibility to thromboembolic disease.5 The risk factors for cancer-associated thrombosis include the type of malignancy, the presence of metastatic disease, and the use of chemotherapy. In most patients with cancer, a procoagulant state can be identified, ranging from subclinical laboratory abnormalities to full-blown disseminated intravascular coagulation. The presence of TMA that is specifically related to chemotherapy or to radiotherapy is a unique entity.
TMA is a severe and rare condition that could be fatal. It is characterized by microangiopathic hemolytic anemia, thrombocytopenia, and organ involvement, including renal failure, neurologic abnormalities, and gastrointestinal symptoms.
The pathogenesis of TMA is complicated and multifactorial. Adverse reactions to drug therapy are increasingly reported as potential causes of TMA. Mitomycin is the most common antineoplastic drug known to be associated with TMA.6 Many other chemotherapeutic agents have been implicated in the etiology of TMA, such as 5-fluorouracil, bleomycin, cisplatin, gemcitabine, sunitinib, fludarabine, and docetaxel.5,7 It has been reported that fludarabine induces apoptosis, activation, and alloreactivity of human endothelial cells, as well as causes damage to the dermal and alveolar epithelial cells.8 The effect of fludarabine on endothelial cells may contribute to the pathogenesis of TMA after a patient receives the FLAG-IDA regimen.8 Furthermore, G-CSF has been associated with this effect as well.9,10
Besides the direct injury to the endothelium, the activation of an underlying autoimmune disease has also been proposed as a possible mechanism for TMA that is associated with G-CSF.9,10
Classic idiopathic TMA is associated with severe deficiency or inhibition of the plasma metalloprotease ADAMTS13. This protease specifically cleaves von Willebrand factor, thereby reducing its multimeric size. Inherited or acquired deficiencies of ADAMTS13 impair von Willebrand factor cleavage, leading to the disseminated formation of platelet-rich thrombi in the microcirculation and to symptoms of organ ischemia.11 Idiopathic TMA is characterized by inhibition of ADAMTS13 by an autoantibody, thus causing accumulation of unusually large von Willebrand factor multimers, which are implicated in the formation of platelet aggregates.11
Basic science discoveries in the late 1990s now suggest that the most likely mechanisms by which chemotherapeutic agents lead to a thrombotic microangiopathy include an immune-mediated phenomenon involving the ADAMTS13 metalloprotease or a direct endothelial toxicity.12 However, many aspects of the complex biologic relationship between von Willebrand factor–cleaving metalloproteinase and acquired TMA are still unclear. In chemotherapy-induced TMA, the pathogenic mechanism appears to be associated with direct endothelial damage, not with the ADAMTS13 deficiency described in idiopathic TMA.13 In this sense, fludarabine has been associated with post–stem-cell transplantation TMA.13
Although the diagnosis of TMA is based on recognizing microvascular thrombosis, red blood cell destruction, and platelet consumption, no guidelines are available to completely define TMA or its severity. The Common Terminology Criteria for Adverse Events (CTCAE) provides similar definitions to TTP-HUS.14 Based on the CTCAE, the grade of the case discussed here would be 5 (ie, death).
The role of therapeutic plasma exchange is clearly stated in idiopathic TMA, but its role is discussed in chemotherapy-induced TMA as a result of pathophysiologic differences between TTP-HUS and TMA. Although plasma exchange has improved survival rates and recent advances in understanding the pathogenesis of this syndrome are remarkable, clinical decisions remain empirical. Therefore, the management decisions for patients with suspected TMA rely on individual experience and opinion, resulting in different practice patterns. Multipractice clinical trials are required to define optimal management.15
Experience has shown that rituximab, for example, can be used for the early treatment of chemotherapy-induced TMA, particularly when plasma exchange is not rapidly effective.16 Patients with post–stem-cell transplant TMA refractory to at least 1 week of plasma exchange and prednisolone have been treated with rituximab (375 mg/m2 weekly) and have achieved remission.16 In these patients, levels of ADAMTS13 and anti-ADAMTS13 antibody did not change significantly with rituximab-induced remission. Because the course of TMA is unpredictable, the role of rituximab in such cases requires rigorous investigation.17
The Naranjo Adverse Drug Reaction probability scale is a simple and widely used nonspecific questionnaire-based scale developed for the assessment of adverse drug reactions.18 In the case of our patient, it suggests a probable relationship between TMA and the FLAG-IDA regimen (Table 3).
Chemotherapy-induced TMA is difficult to diagnose, because of the uncertainty regarding the diagnosis of TMA, and its presentation overlaps with other side effects that are associated with chemotherapy (ie, cytopenias, renal failure, neurologic disorders). Therefore, the diagnosis of chemotherapy-induced TMA requires a high level of clinical suspicion.
We have not found in the literature any case report implicating the FLAG-IDA regimen with thrombotic microangiopathy.
Conclusion
TMA is a severe and rare complication after chemotherapy. The presence of thrombocytopenia and microangiopathy, markedly increased lactate dehydrogenase, and fragmented red blood cells in peripheral blood film, in the absence of alternative apparent etiologies, requires a high level of clinical suspicion. Our case shows that it can be provoked by various agents, and that it can be fatal despite early treatment.
Fludarabine and G-CSF have been reported as causative agents of the TMA by several mechanisms. Because it is difficult to diagnose chemotherapy-induced TMA as a result of its presentation that is overlapping with other complications, hematologists must be aware of this syndrome to ensure the rapid initiation of treatment. Further research into the optimal management of the patients with TMA is required.
Author Disclosure Statement
Dr Montoro, Dr Gómez, Dr Tormo, Dr Torrecillas, and Dr Calabuig had no conflicts of interest to report.
References
1. de la Rubia J, Regadera A, Martín G, et al. FLAG-IDA regimen (fludarabine, cytarabine, idarubicin and G-CSF) in the treatment of patients with high-risk myeloid malignancies. Leuk Res. 2002;26:725-730.
2. Hollenbeck M, Kutkuhn B, Aul C, et al. Haemolytic-uraemic syndrome and thrombotic-thrombocytopenic purpura in adults: clinical findings and prognostic factors for death and end-stage renal disease. Nephrol Dial Transplant. 1998;13:76-81.
3. Medina PJ, Sipols JM, George JN. Drug-associated thrombotic thrombocytopenic purpura-hemolytic uremic syndrome. Curr Opin Hematol. 2001;8:286-293.
4. Elliott MA, Nichols WL. Thrombotic thrombocytopenic purpura and hemolytic uremic syndrome. Mayo Clin Proc. 2001;76:1154-1162.
5. Moya-Horno I, Querol Niñerola R, Bonfill Abella T, et al. Haemolytic uraemic syndrome associated with gemcitabine. Clin Transl Oncol. 2010;12:381-383.
6. D’Elia JA, Aslani M, Schermer S, et al. Hemolytic-uremic syndrome and acute renal failure in metastatic adenocarcinoma treated with mitomycin: case report and literature review. Ren Fail. 1987;10:107-113.
7. Zakarija A, Bennett C. Drug-induced thrombotic microangiopathy. Semin Thromb Hemost. 2005;31:681-690.
8. Eissner G, Multhoff G, Gerbitz A, et al. Fludarabine induces apoptosis, activation, and allogenicity in human endothelial and epithelial cells: protective effect of defibrotide. Blood. 2002;100:334-340.
9. Naina HV, Gertz MA, Elliott MA. Thrombotic microangiopathy during peripheral blood stem cell mobilization. J Clin Apher. 2009;24:259-261.
10. Kovacic JC, Macdonald P, Freund J, et al. Profound thrombocytopenia related to G-CSF. Am J Hematol. 2007;82:229-230.
11. Mannucci PM, Peyvandi F. TTP and ADAMTS13: when is testing appropriate? Hematology Am Soc Hematol Educ Program. 2007:121-126.
12. Plaimauer B, Zimmermann K, Völkel D, et al. Cloning, expression, and functional characterization of the von Willebrand factor-cleaving protease (ADAMTS13). Blood. 2002;100:3626-3632.
13. Shimoni A, Yeshurun M, Hardan I, et al. Thrombotic microangiopathy after allogeneic stem cell transplantation in the era of reduced-intensity conditioning: the incidence is not reduced. Biol Blood Marrow Transplant. 2004;10:484-493.
14. National Institutes of Health. Common Terminology Criteria for Adverse Events (CTCAE): Version 4.0. May 28, 2009. Version 4.03, revised June 14, 2010. http://evs.nci.nih.gov/ftp1/CTCAE/CTCAE_4.03_2010-06-14_QuickReference _8.5x11.pdf. Accessed August 21, 2013.
15. George JN. How I treat patients with thrombotic thrombocytopenic pur-
pura-hemolytic uremic syndrome. Blood. 2000;96:1223-1229.
16. Au WY, Ma ES, Lee TL, et al. Successful treatment of thrombotic microangiopathy after haematopoietic stem cell transplantation with rituximab. Br J Haematol. 2007;137:475-478.
17. Gourley BL, Mesa H, Gupta P. Rapid and complete resolution of chemotherapy-induced thrombotic thrombocytopenic purpura/hemolytic uremic syndrome (TTP/HUS) with rituximab. Cancer Chemother Pharmacol. 2010;65:1001-1004.
18. Naranjo CA, Busto U, Sellers EM, et al. A method for estimating the probability of adverse drug reactions. Clin Pharmacol Ther. 1981;30:239-245.